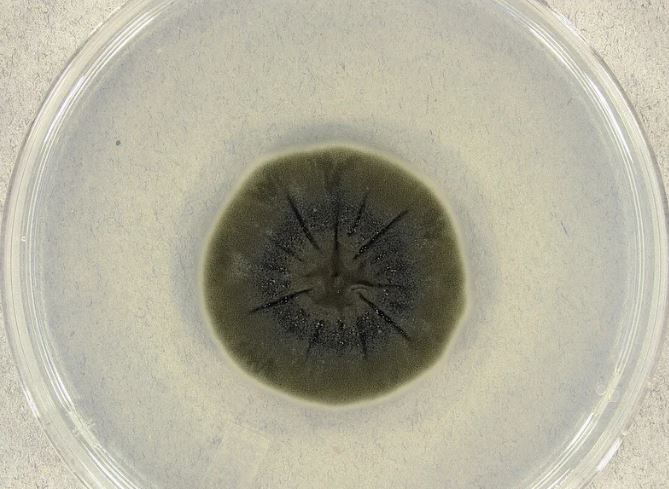

اكتشاف كائن حي قادر على تنظيف منطقة كارثة تشيرنوبيل
عثر العلماء على كائن حي لايمكنه فقط الحياة داخل منطقة كارثة تشيرنوبيل، وهو لا يتحمل بعضًا من أقسى ظروف المعيشة التي يمكن تخيلها فحسب، بل إنه قد يساعد في تحسين تلك البيئة أيضًا.
وفيما لاتزال تداعيات كارثة تشيرنوبيل النووية في عام 1986 تثير اهتمام المجتمع العلمي بعد مرور ما يقرب من 40 عامًا على تلك الواقعة، ظهرت تطورات علمية جديدة تبشر بإمكانية التخلص من التلوث الإشعاعي الذي يخيم على المنطقة.
تتميز منطقة تشيرنوبيل المحظورة في أوكرانيا بمستوى من الإشعاع يبلغ ستة أضعاف الحد القانوني للتعرض البشري للعمال عند 11.28 ميلي ريم - ولكن لا يزال هناك كائن حي تكيف للعيش والنمو هناك.
واكتشف العلماء فطرًا أسود اللون داخل المنطقة المحظورة التي يبلغ قطرها 30 كيلومترًا، وعثر الباحثون على الفطر ينمو على جدران المفاعل رقم 4 حيث حدث الانهيار الأول.
وأظهرت الدراسة أن الفطر الأسود ازدهرت بالفعل حيث كان الإشعاع في أعلى مستوياته.
ونشرت في المكتبة الوطنية للطب أن مفتاح قدرة تلك الفطريات يكمن في إنها تستطيع على استهلاك الإشعاع عبر الميلانين الذي تمتلكه، والذي يسمح للكائنات الحية بامتصاص الإشعاع وتحويله إلى طاقة .
وبدأ الخبراء في التفكير في إمكانية استخدام الفطر لتقليل مستويات الإشعاع، كما يمكن أن تلعب دورًا أكبر في تنظيف واحدة من أكثر الأجواء عدائية على وجه الأرض.
ونصت المقالة: "إن النتائج التي توصلنا إليها من خلال دراسة الكائنات الحية المصطبغة في بيئات ذات إشعاعات عالية مثل المفاعل التالف في تشيرنوبيل، ومحطة الفضاء، وجبال القارة القطبية الجنوبية، ومياه تبريد المفاعل، إلى جانب ظاهرة "التوجه الإشعاعي"، تثير احتمالية مثيرة للاهتمام مفادها أن الميلانين له وظائف مماثلة لوظائف أصباغ حصاد الطاقة الأخرى مثل الكلوروفيل".

يأتي ذلك بعد أن كشف العلماء عن تفاصيل مثيرة للاهتمام حول الديدان المجهرية في منطقة الكارثة، ووجد الباحثون أن هذه المخلوقات الصغيرة لم تظهر عليها أي علامات محسوسة على الضرر الجيني الناجم عن التعرض للإشعاع، وقد تلعب دورًا كبيرًا في الدراسات المستقبلية حول السرطان.
ويأتي ذلك بعد أن كشفت دراسة أن أعداد الذئاب التي تعيش في ظروف قاسية حول تشيرنوبيل قد تغيرت إلى حد أنها أصبحت الآن أكثر قدرة على مقاومة السرطان .
تابعوا آخر أخبار بوابة الوفد الإلكترونية عبر نبض